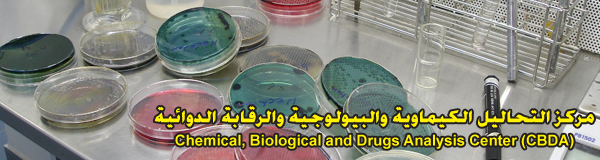

The University Participates in an Intensive Training Course in India
12 October 2010
Between August 4th and September 28th 2010, Mr. Mohammad Abdel Qader Mousa, Lab Superintendent at the Chemical, Biological and Drugs Analysis Center (CBDA) at An-Najah, and Engineer Muhammad Nassar from the Palestine Polytechnic University in Hebron participated in an intensive 8-week advanced training certificate course for overseas teachers titled "Water Quality Analysis-Laboratory Practice".
The course was organized at the National Institute of Technical Teachers Training and Research (NITTTR) in Taramani, Chennai, India. The NITTTR is an autonomous institute under Department of Higher Education at the Ministry of Human Resource Development in India. It has the objective of improving technical education through curriculum and industrial material development, staff development, research and extension service.
The course was administered by Dr. S. Mohan, Director of the NITTTR and course Coordinator, as well as Dr. G. Janardhanan, as Co-Coordinator. Participants from different nationalities including Switzerland, Austria, India, Iraq, Sudan, South Africa, Venezuela, Zambia, Guyana Islands and Palestine took part in the event. The course addressed a number of issues related to water, environment, and health including: Water science and water quality, water quality indicator, climate change and its impact on water quality, sampling and analysis of river water quality, laboratory practice sessions (Biochemical Oxygen Demand (BOD), Chemical Oxygen Demand (COD), Chloride, Nitrate, Sulphate, Dissolved Oxygen, PH, Conductivity, Acidity, Alkalinity).
Other topics included: GIS, GPS and their applications, statistic for water science, Statistical Package for the Social Sciences (SPSS) and its applications, quality control in water testing laboratories, statistical quality control, using Water Quality Analysis Simulation Program (WASP), water quality mass balance modeling, microbial analysis of water and ground water quality and health.
During the 8 weeks of the course, both Mr. Abdel Qader and Engineer Nassar delivered two lectures titled "Focuses on the Source and Quality of Water in Palestine" along with a short film prepared by the Palestinian Water Ministry that described water status in Palestine. The other lecture was titled "Environmental Education in Palestine" which was also presented along with a film that described the excellent water characteristics. The lectures were delivered at Coimbatore Institute of Technology, Coimbatore, India at the International Seminar on Role of Environmental Education in the Global Engineering Curricula in September 20th 2010.
Abdel Qader also conducted a scientific research both theoretical and practical titled "Adsorption of Pb2+ Ions from Aqueous Solutions by Polyalthia Longifolia (Green Champa) Tree Leaves". The other research was titled "Ensure Stability of the Amount of Lead Pb2+ Ions Adsorption by the Polyalthia Longifolia (Green Champa) Tree Leaves Powder". The research focused on this particular tree (Green Champa / Polyalthia Longifolia) which is native to India and Sri Lanka. After presenting his research, Abdel Qader discussed the results of the research which turned to be excellent and highly applicable. He explained that the tree is found all over India and has a great ability to absorb lead from water. The research received positive reviews and won the admiration of the staff at the research center.
In addition to its scientific discussions, lectures and training sessions, the course included visits to different locations such as the visit to the Central Ground Water Body-Laboratory, visit to the Tamil Nadu Waste Management Limited-Field and Laboratory, visit to the National Environmental Engineering Research Institute-Microbiological Laboratory, visit to the Kilpauk Water Treatment Plant, visit to the Tamil Nadu Pollution Control Board-Environmental Laboratory, visit to the Chennai MWSB-Koyambedu and Redhills.
The course included training the participants on quality testing mechanism, the use of modern devices, conducting key research and other skills. Through their participation in the event, Mr. Abdel Qader and Engineer Nassar were able to familiarize their colleagues from other countries with Palestine, water resources there, and the sources of pollution that affect the Palestinian water sector. It was also a chance to introduce An-Najah University and its CBDA which dedicates it services to try to promote awareness regarding water status among Palestinians and internationals.
At the end of the course the participants were granted certificates in appreciation for their participation and in recognition of their research work and valuable presentations. Abdel Qader mentioned that the course was a major success and described his participation as an important addition to his knowledge and experience. He also thanked the University's administration for the support it provided which facilitated his participation in the course.